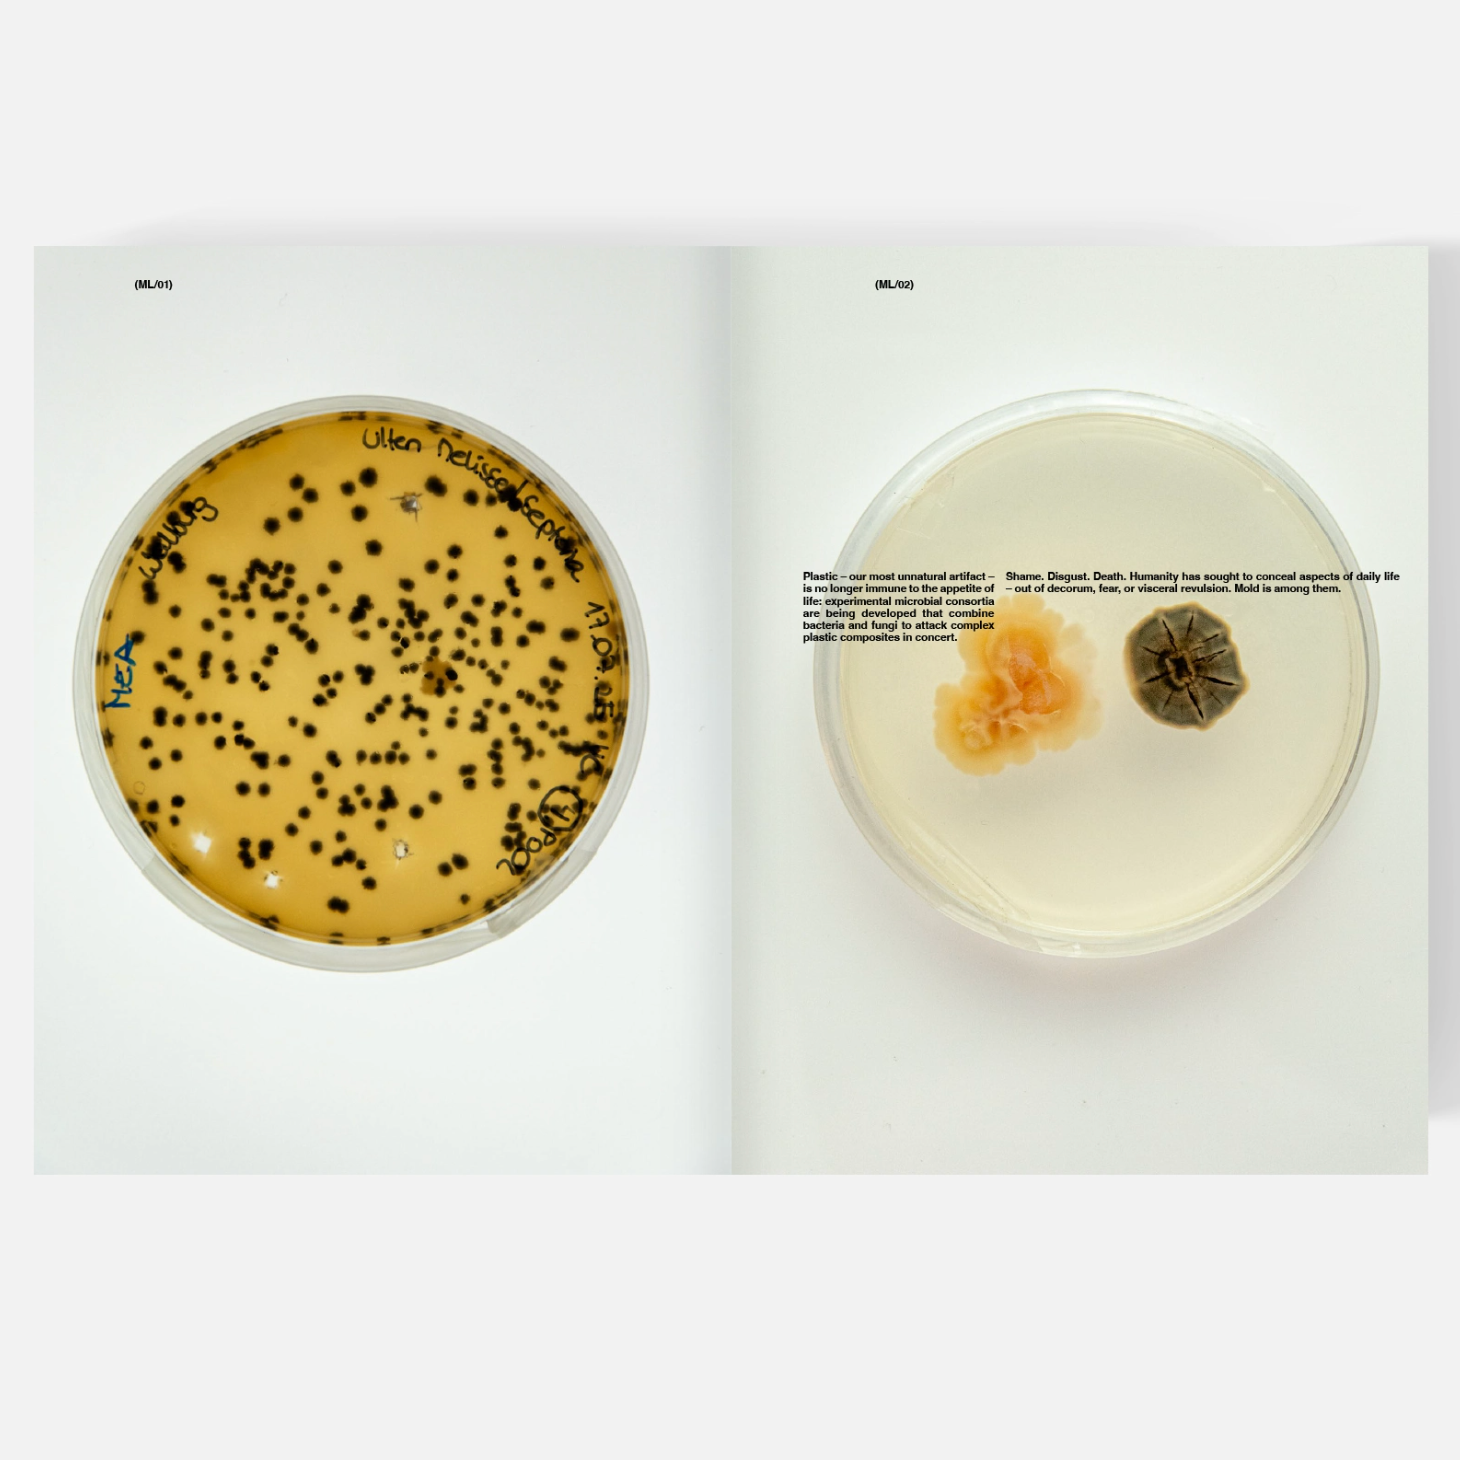

LAMPOON issue 32 : Soap
- Éditeurs: LAMPOON MAGAZINE
- Date de publication: 2025-10-22
We Like It Soapy and Dirty – Fall 2025
SOAP is the title of the new issue of Lampoon Magazine Fall 2025, released worldwide from October 22nd.
Lampoon SOAP is a journey through stains, purity, and contradiction – a visual and textual exploration that stretches from microplastics in oceans to blood on our hands. Soap as the act of cleansing, but also as metaphor: of moral stains, of humanity’s endless cycle of defeat and renewal. Soap is never just soap. It washes, it heals, it purifies – but it also reveals.
Lampoon 32 SOAP dives into the paradox: what does it mean to be clean, when the act of cleaning dirties the water itself? From polluted rivers to stained consciences, this issue uncovers the truth that every life carries its own grime, that sincerity emerges only through contradiction.
We follow the slimy traces of snails in Vienna and Madrid, commission a hemp-based artisanal soap, and photograph Ignazio Gardella’s Tuberculosis asylum. Microscopes, bacteria and molds, imagining the biotechnological futures of microplastic digestion. Sofia Alazraki’s still-lifes are dirty, sticky, refusing polish. François Berthoud says it straight: he doesn’t want to look at the computer anymore. Olivier Zahm and Annabelle Wearthly melt under the sun until they blur. Naguel Rivero keeps fashion stripped to the bone. Mircea Cantor carves Aleppo soap into shapes that still carry the smell of war. Along the Ganges, Rid Burman photographs the collision of sacred water and floating plastic. A tribute to Mr. Giorgio Armani – archival shots mixed with artificial intelligence
Share